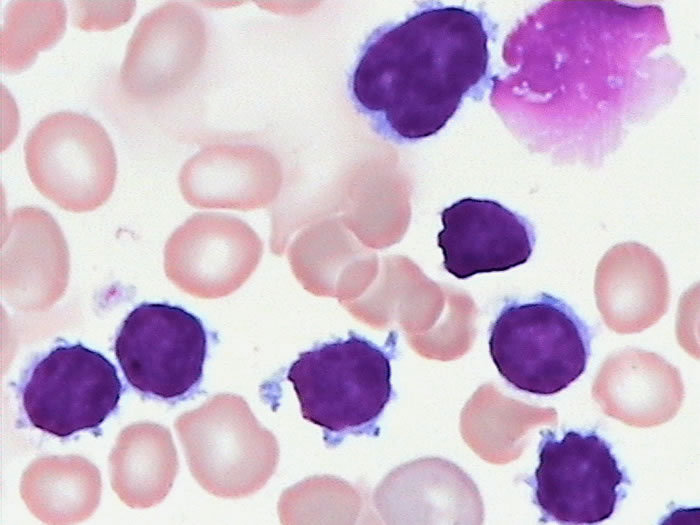
p data-id="go1a345pnn">巨核细胞(megakaryocyte)是骨髓中的一种从
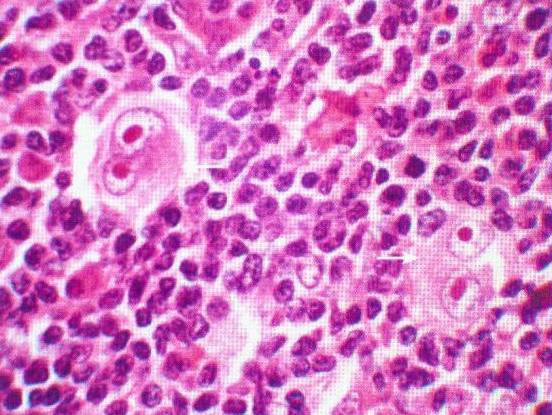
镜影细胞

megakaryocytes

megakaryocyte production of platelets
图片尺寸700x517
megakaryocyte and platelets
图片尺寸1013x1500
p data-id="go1a345pnn">巨核细胞(megakaryocyte)是骨髓中的一种从
图片尺寸700x525
bdnf protein levels in mouse, rat, and human megakaryocytes and
图片尺寸512x763
clec-2 in megakaryocytes is critical for maintenance of
图片尺寸1201x1280
hematox megakaryocyte kit/hematox 巨核分化试剂盒
图片尺寸499x373
镜影细胞
图片尺寸552x415
单核巨噬细胞,dc, γδt细胞,nk,t细胞和b细胞抑制高血压: mdscs
图片尺寸674x643
肺泡灌洗液免疫组化:cd68( ),cd1a(少量 ),ck(ae1/ae3)(散在 ),s-100
图片尺寸797x371
megakaryocytes possess a functional intrinsic apoptosis pathway
图片尺寸1280x1227
海外直订医药图书megakaryocytes, platelets, macrophages, and
图片尺寸800x800
megakaryocytes possess a functional intrinsic apoptosis pathway
图片尺寸1016x1280
点击空白处查看答案组织活检病理结果:通过 s-100 蛋白免疫组织
图片尺寸900x531
镜影细胞
图片尺寸700x507
plateletsandmegakaryocytesvolume4advancedprotocolsand
图片尺寸1052x1536
髓系肿瘤:骨髓增殖性肿瘤
图片尺寸1280x960
platelet-producingmegakaryocyte2.neutrophilicstabcell3.
图片尺寸1143x912
granularmegakaryocytes2.nude-nuclearmegakaryocyte .
图片尺寸1121x878
gf实际上赋予了mega路卡利欧适应性.
图片尺寸1600x1200
有人在评论里提到了mega于是.
图片尺寸500x500